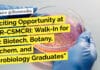
Exciting Opportunity at CSIR-CSMCRI: Walk-In for BSc Biotech, Botany, Biochem, and Microbiology Graduates "Exciting Opportunity at CSIR-CSMCRI: Walk-In for BSc Biotech, Botany, Biochem, and Microbiology Graduates"

IISER Mohali MSc & BTech Life Sciences Research Fellow Job
IISER Mohali Research Fellow Job For Life Sciences
IISER Mohali Research Fellow Job For Life Sciences. Research Fellow Job for msc & btech life sciences...
VIT Vellore Cell Line Development Research Fellow Recruitment
VIT Vellore Jobs - Junior Research Fellow Vacancy
VIT Vellore Jobs - Junior Research Fellow Vacancy. Biotech Jobs. MSc Biochemistry/ Molecular Biology/ Genetic Engineering/ Biotechnology/...
Cognizant Life Sciences Process Specialist – Data Recruitment
Cognizant Data Specialist Jobs For Life Sciences, Apply Online
Cognizant Data Specialist Jobs For Life Sciences, Apply Online. Life Sciences Process Specialist - Data position...
NIAB Life Sciences Project Assistant Recruitment, Applications Invited
NIAB Life Sciences Project Assistant Recruitment, Applications Invited
NIAB Life Sciences Project Assistant Recruitment, Applications Invited. National Institute of Animal Biotechnology (NIAB) is hiring for...
NICPR Bioinformatics Research Fellow in Cancer Project Recruitment
NICPR Bioinformatics Research Fellow in Cancer Project Recruitment
NICPR Bioinformatics Research Fellow in Cancer Project Recruitment. MSc & MTech Bioinformatics etc. candidates can apply. Interested...
Biotecnika Times Newsletter 30.08.2021 – Hindustan Coca-Cola Recruitment, IISc Hiring, Apply
Biotecnika Times - Hindustan Coca-Cola Recruitment, IISc Hiring, Apply
Hindustan Coca-Cola Beverages Executive Quality Assurance Recruitment
Coca-Cola India Jobs – Executive Quality Assurance Recruitment. Hindustan Coca-Cola...
Wildlife Institute of India Life Sciences Research Fellow Recruitment
WII SRF Job Opening - Life & Biological Sciences Apply
WII SRF Job Opening - Life & Biological Sciences Apply. WII Dehra Dun jobs for...
IISc Exclusively Hiring Life Science Candidates For Post of JRF / SRF (KSS lab)
IISc Exclusively Hiring Life Science Candidates For Post of JRF / SRF (KSS lab)
Description of Lab: Cancer development is a complex process involving the...
ICGEB Research Associate & Post-Doc Recruitment, Applications Invited
ICGEB Research Associate & Post-Doc Recruitment, Applications Invited
ICGEB Research Associate & Post-Doc Recruitment, Applications Invited. MSc/ MTech & PhD Computational Biology/ Bioinformatics/ Life sciences/...
BIRAC Funded Project Research Associate Job at NII, Applications Invited
Research Project Associate Jobs at NII - Applications Invited
Research Project Associate Jobs at NII - Applications Invited. Recruitment of PhD Biology and Life Sciences...
ICMR-National Institute of Pathology Cancer Project Job With Rs. 59,000 pm Pay
ICMR NIP Jobs - Non Medical Scientist Recruitment For Life Science
ICMR NIP Jobs - Non Medical Scientist Recruitment For Life Science. ICMR-National Institute of...
PhD in Singapore? Apply for Singapore International Graduate Award (SINGA)
SINGA 2022: Singapore International Graduate Award
SINGA 2022: Singapore International Graduate Award. Interested candidates from all over the globe are eligible to apply for the...
Multi-stage Vaccine Candidates Project Research Fellow Recruitment
Research Project Fellow Jobs at NII - Applications Invited
Research Project Fellow Jobs at NII - Applications Invited. Recruitment of MSc/MTech Biology and Life Sciences...
Govt IBSD Research Associate Job With Rs. 54,000 pm Salary
IBSD Research Jobs - Life Sciences Associate Vacancy
IBSD Research Jobs - Life Sciences Associate Vacancy. PhD Biotechnology/ Microbiology/ Bioinformatics/ Life sciences candidates are encouraged...
NIRRH Molecular Biology Research Fellow Recruitment, Apply Online
NIRRH Mol Bio Jobs - Junior Research Fellow Vacancy
NIRRH Mol Bio Jobs - Junior Research Fellow Vacancy. NIRRH recruitment for MSc Molecular Biology candidates....